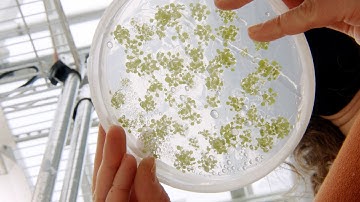
Revolutionizing Agriculture with Low Emissions, Resilient Crops

⬇ DOWNLOAD NOW
Kalau muncul iklan pop-up, tutup lalu klik tombol kembali
Download lagu Securing a resilient future for agriculture through connections between technology and practice secara gratis hanya untuk keperluan promosi. Dukung artis favorit kamu dengan membeli musik original di iTunes atau platform resmi lainnya.
 How "Resilient Agriculture" creates a sustainable future | ncIMPACT | PBS North Carolina
How "Resilient Agriculture" creates a sustainable future | ncIMPACT | PBS North Carolina
Revolutionizing Agriculture with Low Emissions, Resilient Crops
Revolutionizing Agriculture with Low Emissions, Resilient Crops
 The Future of Agriculture Technology is Now
The Future of Agriculture Technology is Now
 The innovations and ideas changing agriculture, part one
The innovations and ideas changing agriculture, part one
 Advancing Agri-Tech: Empowering Farmers through Innovation
Advancing Agri-Tech: Empowering Farmers through Innovation
 Technology, agriculture's friend for the sustainable farms of the future
Technology, agriculture's friend for the sustainable farms of the future
 Climate Smart Agriculture for a resilient coastal Bangladesh (Short version)
Climate Smart Agriculture for a resilient coastal Bangladesh (Short version)
 Climate Resilient Agriculture Technology | Amazing Farming Practice to get More Yield
Climate Resilient Agriculture Technology | Amazing Farming Practice to get More Yield